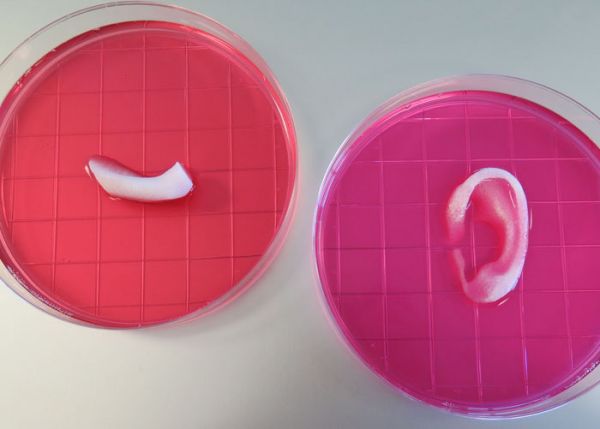

各省、自治区、直辖市人民政府,国务院有关部门:

美国的商业长期护理险发展得并不成功,占整个长期护理市场支付的不到10%的,且近年来的发展趋势是增速持续下降。

5月2日,据GEN网站报道,比利时的Celyad公司授予了诺华关于其同种异体CAR-T技术的一项非独占许可。

近日,在2017中国“互联网+”数字经济峰会上。

干细胞,即一种未充分分化,具有增殖和分化潜能,具有自我更新复制能力,能够产生高度分化的功能细胞。

胃肠道的电子设备有望变革胃肠道的诊断和治疗模式。

今天葛兰素的基因疗法、ADA-SCID药物Strimvelis在上市近一年后迎来第一位使用患者,这也是继那位使用首个基因...

韩国政府近日表示,医疗目的访问韩国的外国人数量2016年同比增长了23%.
随着A股上市企业年报披露落下帷幕,第一季度报告成为各家关注的新重点。
患有肾病的人移植器官要等待三至五年,在有的国家甚至要更久。等待移植胰腺的病人要排两年的队。

在一个阳光明媚的上午,Dr.2兴高采烈的去喜来登,听行业内大腕谦哥与刘俊的培训课。

自从2012年“天价海鲜”事件曝光后,海南的旅游业经历了“冰火两重天”。游客数量出现一定程度地下滑,连续三年客房数增长大...

吉利德5月2日公布2017Q1季报,实现总收入65.05亿美元。

就像克隆了一个经验丰富的眼科医生,通过云服务完成自动诊断。

“我国的医疗服务体系服务的对象近14亿,每年产生近80亿的诊疗量,如何保障、评价医疗系统的质量和安全,医疗评审与评价制度...
2026-02-06
2026-02-05
2026-02-05
2026-02-04
2026-02-04

